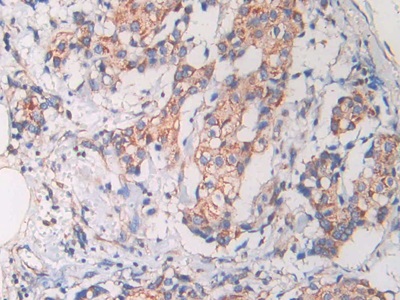
https://d1vffmuvmgkypt.cloudfront.net/image/ridacom_ltd/cloud_clone_corp/PRODUCT_SOURCE__CLOUD_CLONE__SUPPLIER__RIDACOM__ID__MAC419Hu28__1

Antigen
CAP18
Reactivity
Human
(9)
Mouse
(4)
Rat
(4)
Clonality
Monoclonal
(3)
Polyclonal
(3)
Application
Western Blotting
(11)
Immunocytochemistry
(7)
Immunohistochemistry
(7)
Enzyme-linked immunosorbent assay for Antigen Detection
(6)
Immunoprecipitation
(6)
SDS-PAGE
(4)
Positive Control
(3)
Test method
Competitive Inhibition
(3)
Double-antibody Sandwich
(3)
Host
Mouse
(3)
Rabbit
(3)
CHO
(1)
Category
Antibodies
(7)
ELISA Kits
(6)
Cell biology
(4)
Immunochemicals
(4)
Protein Biochemistry
(4)
| 48T | $595.00 | |
| 96T | $850.00 | |
| 96T*5 | $3,825.00 |
| 96T*10 | $7,225.00 | |
| 96T*100 | $59,500.00 |
| 48T | $567.00 | |
| 96T | $810.00 | |
| 96T*5 | $3,645.00 |
| 96T*10 | $6,885.00 | |
| 96T*100 | $56,700.00 |
| 48T | $504.00 | |
| 96T | $720.00 | |
| 96T*5 | $3,240.00 |
| 96T*10 | $6,120.00 | |
| 96T*100 | $50,400.00 |
| 48T | $490.00 | |
| 96T | $700.00 | |
| 96T*5 | $3,150.00 |
| 96T*10 | $5,950.00 | |
| 96T*100 | $49,000.00 |
| 48T | $489.00 | |
| 96T | $698.00 | |
| 96T*5 | $3,141.00 |
| 96T*10 | $5,933.00 | |
| 96T*100 | $48,860.00 |
| 48T | $476.00 | |
| 96T | $680.00 | |
| 96T*5 | $3,060.00 |
| 96T*10 | $5,780.00 | |
| 96T*100 | $47,600.00 |

Antigen:
Cathelicidin Antimicrobial Peptide
Synonyms: CAP18; FALL39; HSD26; LL37; 18 kDa Cationic Antimicrobial Protein; Antibacterial protein FALL-39; FALL-39 peptide antibiotic
Reactivity:Human
Application:Positive Control; SDS-PAGE; Western Blotting
Research area:Infection immunity
Preparation method:Escherichia coli
| 10µg | $204.00 | |
| 50µg | $510.00 | |
| 200µg | $1,020.00 |
| 1mg | $3,060.00 | |
| 5mg | $7,650.00 |

Antigen:
Cathelicidin Antimicrobial Peptide
Synonyms: CAP18; FALL39; HSD26; LL37; 18 kDa Cationic Antimicrobial Protein; Antibacterial protein FALL-39; FALL-39 peptide antibiotic
Reactivity:Rat
Application:Positive Control; SDS-PAGE; Western Blotting
Research area:Infection immunity
Preparation method:Escherichia coli
| 10µg | $193.00 | |
| 50µg | $482.00 | |
| 200µg | $964.00 |
| 1mg | $2,892.00 | |
| 5mg | $7,230.00 |

Antigen:
Cathelicidin Antimicrobial Peptide
Synonyms: CAP18; FALL39; HSD26; LL37; 18 kDa Cationic Antimicrobial Protein; Antibacterial protein FALL-39; FALL-39 peptide antibiotic
Reactivity:Mouse
Application:Positive Control; SDS-PAGE; Western Blotting
Research area:Infection immunity
Preparation method:Escherichia coli
| 10µg | $178.00 | |
| 50µg | $446.00 | |
| 200µg | $892.00 |
| 1mg | $2,676.00 | |
| 5mg | $6,690.00 |

Antigen:
Cathelicidin Antimicrobial Peptide
Synonyms: CAP18; FALL39; HSD26; LL37; 18 kDa Cationic Antimicrobial Protein; Antibacterial protein FALL-39; FALL-39 peptide antibiotic
Reactivity:Human
Application:SDS-PAGE; Western Blotting
Research area:Infection immunity
| 10µg | $140.00 | |
| 50µg | $350.00 | |
| 200µg | $700.00 |
| 1mg | $2,100.00 | |
| 5mg | $5,250.00 |

Antigen:
Cathelicidin Antimicrobial Peptide
Synonyms: CAP18; FALL39; HSD26; LL37; 18 kDa Cationic Antimicrobial Protein; Antibacterial protein FALL-39; FALL-39 peptide antibiotic
Host:CHO
Reactivity:Human
Application:Western Blotting; Immunohistochemistry; Immunocytochemistry
Research area:Infection immunity
| 20µl | $116.00 | |
| 100µl | $270.00 | |
| 200µl | $386.00 |
| 1ml | $965.00 | |
| 10ml | $3,860.00 |

Antigen:
Cathelicidin Antimicrobial Peptide
Synonyms: CAP18; FALL39; HSD26; LL37; 18 kDa Cationic Antimicrobial Protein; Antibacterial protein FALL-39; FALL-39 peptide antibiotic
Host:Rabbit
Reactivity:Rat
Application:Western Blotting; Immunohistochemistry; Immunocytochemistry; Immunoprecipitation
Clonality:Polyclonal
Research area:Infection immunity
| 20µl | $114.00 | |
| 100µl | $266.00 | |
| 200µl | $380.00 |
| 1ml | $950.00 | |
| 10ml | $3,800.00 |

Antigen:
Cathelicidin Antimicrobial Peptide
Synonyms: CAP18; FALL39; HSD26; LL37; 18 kDa Cationic Antimicrobial Protein; Antibacterial protein FALL-39; FALL-39 peptide antibiotic
Host:Mouse
Reactivity:Human
Application:Western Blotting; Immunohistochemistry; Immunocytochemistry; Immunoprecipitation
Isotype:IgG2a
Clonality:Monoclonal
Research area:Infection immunity
| 20µl | $114.00 | |
| 100µl | $266.00 | |
| 200µl | $380.00 |
| 1ml | $950.00 | |
| 10ml | $3,800.00 |

Antigen:
Cathelicidin Antimicrobial Peptide
Synonyms: CAP18; FALL39; HSD26; LL37; 18 kDa Cationic Antimicrobial Protein; Antibacterial protein FALL-39; FALL-39 peptide antibiotic
Host:Mouse
Reactivity:Human
Application:Western Blotting; Immunohistochemistry; Immunocytochemistry; Immunoprecipitation
Clonality:Monoclonal
Research area:Infection immunity
| 20µl | $111.00 | |
| 100µl | $259.00 | |
| 200µl | $370.00 |
| 1ml | $925.00 | |
| 10ml | $3,700.00 |

Antigen:
Cathelicidin Antimicrobial Peptide
Synonyms: CAP18; FALL39; HSD26; LL37; 18 kDa Cationic Antimicrobial Protein; Antibacterial protein FALL-39; FALL-39 peptide antibiotic
Host:Rabbit
Reactivity:Mouse
Application:Western Blotting; Immunohistochemistry; Immunocytochemistry; Immunoprecipitation
Clonality:Polyclonal
Research area:Infection immunity
| 20µl | $108.00 | |
| 100µl | $252.00 | |
| 200µl | $360.00 |
| 1ml | $900.00 | |
| 10ml | $3,600.00 |

Antigen:
Cathelicidin Antimicrobial Peptide
Synonyms: CAP18; FALL39; HSD26; LL37; 18 kDa Cationic Antimicrobial Protein; Antibacterial protein FALL-39; FALL-39 peptide antibiotic
Host:Rabbit
Reactivity:Human
Application:Western Blotting; Immunohistochemistry; Immunocytochemistry; Immunoprecipitation
Clonality:Polyclonal
Research area:Infection immunity
| 20µl | $105.00 | |
| 100µl | $245.00 | |
| 200µl | $350.00 |
| 1ml | $875.00 | |
| 10ml | $3,500.00 |
Antigen:
Cathelicidin Antimicrobial Peptide
Synonyms: CAP18; FALL39; HSD26; LL37; 18 kDa Cationic Antimicrobial Protein; Antibacterial protein FALL-39; FALL-39 peptide antibiotic
Host:Mouse
Reactivity:Human
Application:Western Blotting; Immunohistochemistry; Immunocytochemistry; Immunoprecipitation
Isotype:IgG2a
Clonality:Monoclonal
Research area:Infection immunity
| 20µl | $102.00 | |
| 100µl | $237.00 | |
| 200µl | $339.00 |
| 1ml | $848.00 | |
| 10ml | $3,390.00 |




-SEC419Hu-000001.png)



-SEC419Ra-000001.png)



-SEC419Mu-000001.png)



-CEC419Mu-000001.png)



-CEC419Ra-000001.png)



-CEC419Hu-000001.png)


-RPC419Hu01-000001.png)



-RPC419Mu01-000001.png)

-CPC419Hu21-000001.png)



















-MAC419Hu28-000001.png)